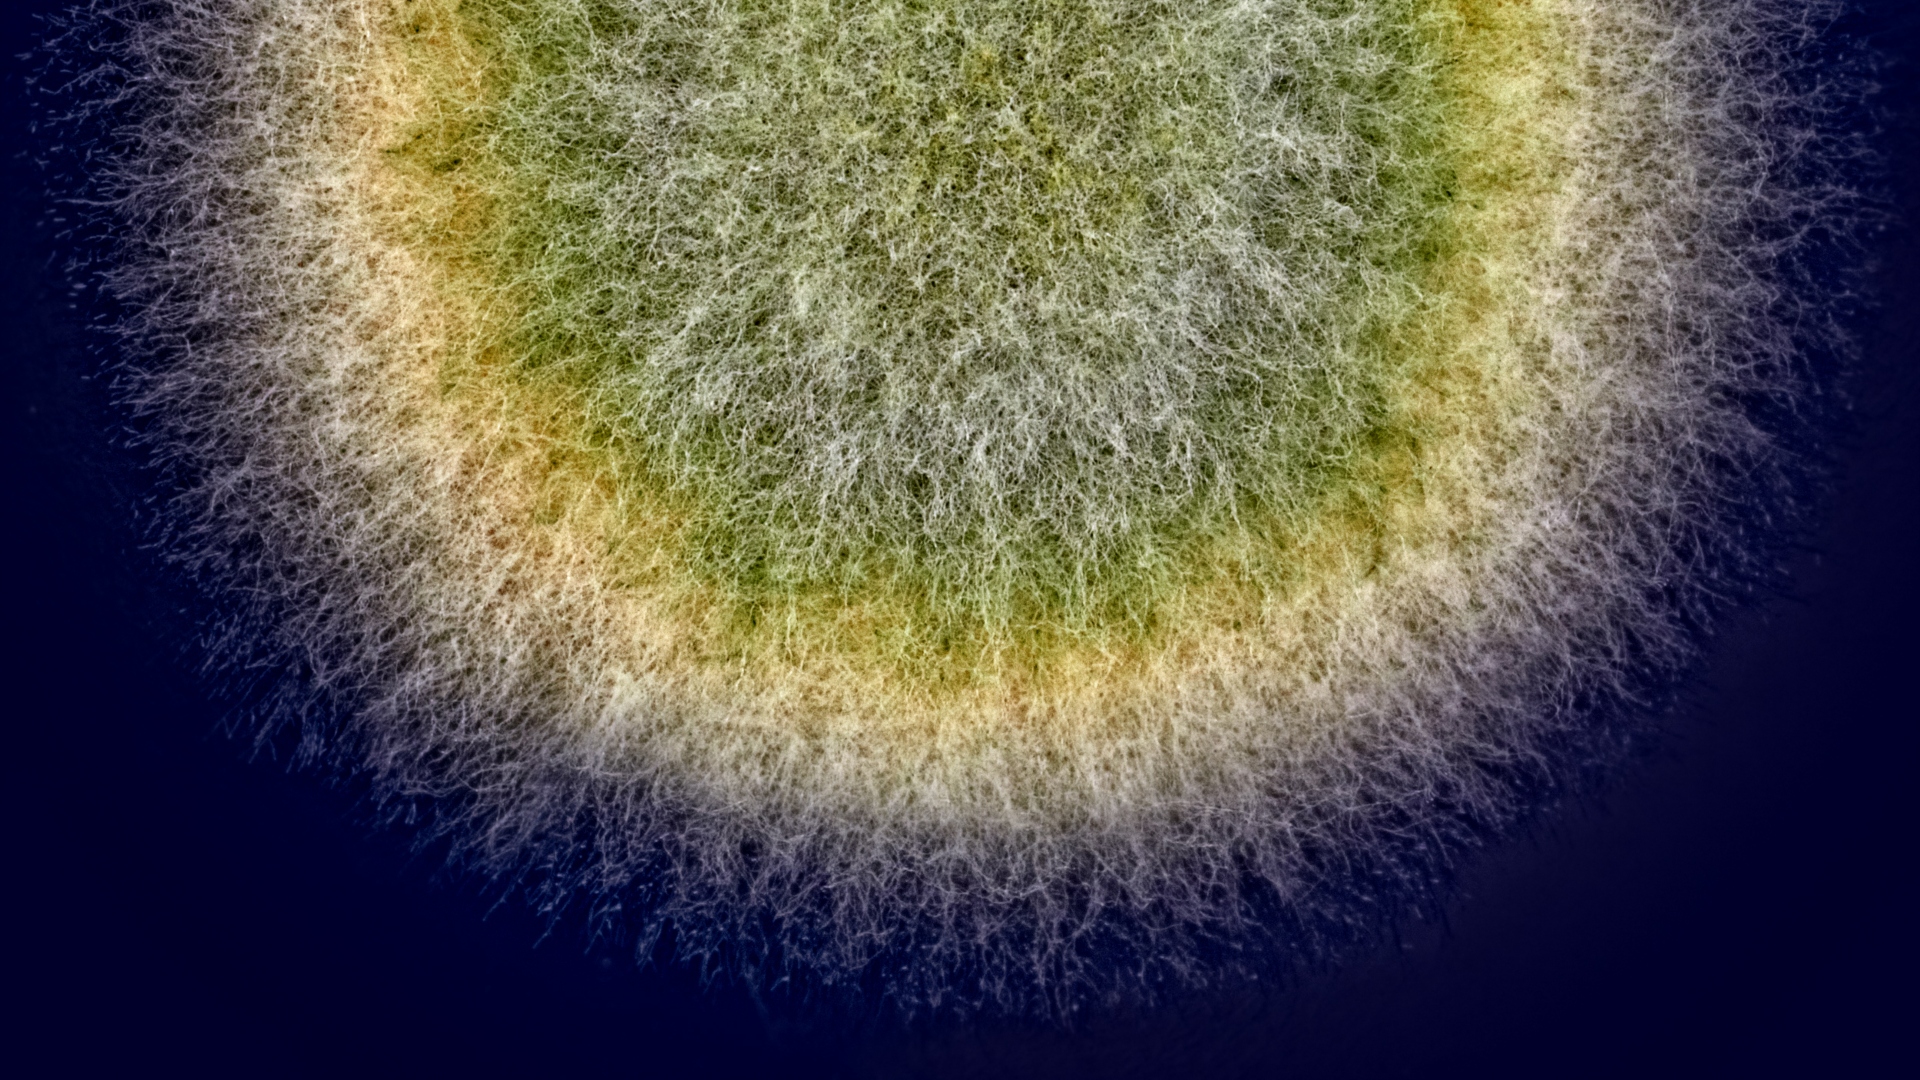
Nærbillede af svampemycelium i grønne og gule nuancer

Svampemagi
Matr sælger en fungibøf og hakket fungi, der har et klimaaftryk på under 10 pct. af det klimaaftryk oksekød har. Produkterne er lavet på naturlige ingredienser som flækærter, kartoffel, rødbede, havre og lupin tilsat naturlige svampesporer. Og det er svampesporerne, som sætter gang i den fermenteringsproces, der skaber magien. Under fermenteringen skaber sporerne nemlig et netværk i de andre ingredienser af små rødder kaldet hyfer, der under et mikroskop til en vis grad minder om kødfibre. Disse netværk af hyfer kaldes også mycelier.
”Mange plantebaserede kødalternativer mangler struktur, og derfor er man nødt til at bruge en række tilsætningsstoffer. Men filamentøse svampe (den gruppe af svampe, der danner hyfer, red.) danner helt naturligt den tekstur og binder det hele sammen,” siger Leoni Johanna Jahn.
Den anden fordel ved svampefermenteringen er, at det udvikler smag. Svampene nedbryder nemlig næringsstofferne til stivelse og aminosyrer, og det giver både sødme og umami.
”Så svampene udvikler en helt ny smag, uden at vi behøver tilsætte noget,” siger hun.
DTU hjælper med at opskalere
Man kan allerede sætter tænderne i Matrs produkter i en række restauranter såsom Gasoline Grill, Sticks’n’ Sushi og Meyer’s Food Truck, ligesom man kan købe deres fungibøf og hakket fungi på nemlig.com. Men målet er at få produktionen op på et højere gear, og her hjælper forskere fra DTU med opskaleringen ved at lave struktur i fungiprodukterne og mikrobiologiske analyser af fermenteringen. Derudover analyserer DTU-forskere også, hvilke komponenter af svampefermenteringen der påvirker smagen.
”Målet er at nå ud til så mange mennesker som muligt med bæredygtig, sund og lækker mad,” siger Leoni Johanna Jahn.